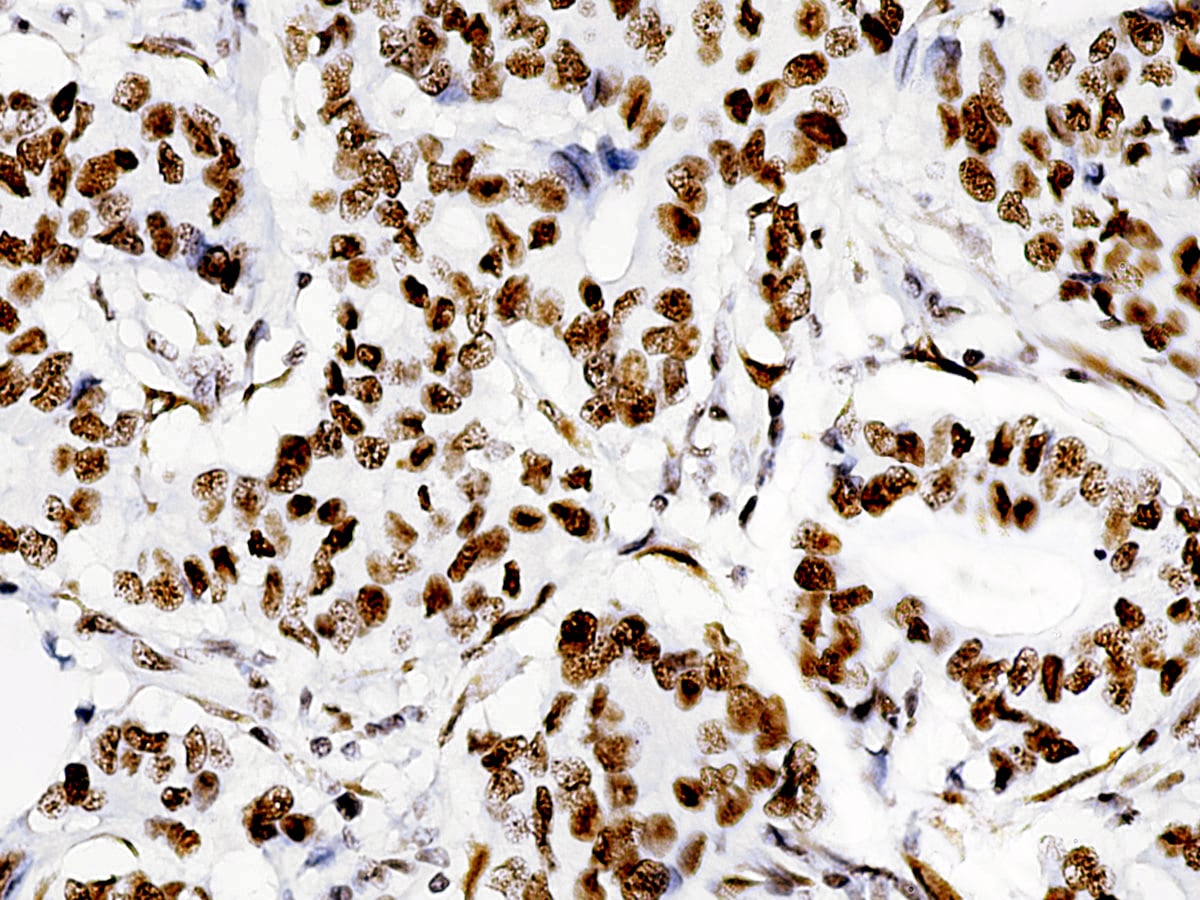
AMB05

Anti-ATRX, Clone D-5
α-thalassemia/mental retardation X-linked (ATRX) is a transcriptional regulator and helicase that belongs to the SNF2 family of chromatin remodeling proteins. Together with its binding partner death-associated protein 6 (Daxx), ATRX acts as histone chaperone to deposit histone variant H3.3 at repetitive DNA sequences such as telomeric, pericentric, and ribosomal gene repeats. It involved in transcriptional regulation and chromatin remodeling. The mutations of this gene are associated with an X-linked mental retardation (XLMR) syndrome most often accompanied by alpha-thalassemia (ATRX) syndrome. These mutations have been shown to cause diverse changes in the pattern of DNA methylation, which may provide a link between chromatin remodeling, DNA methylation, and gene expression in developmental processes. This protein is found to undergo cell cycle-dependent phosphorylation, which regulates its nuclear matrix and chromatin association, and suggests its involvement in the gene regulation at interphase and chromosomal segregation in mitosis. Research studies indicate that the loss of ATRX protein occurs in numerous cancers, including pancreatic neuroendocrine tumors (PanNETs) and pediatric glioblastoma, where telomere maintenance occurs independently of telomerase.
| Intended Use | IVD |
|---|---|
| Antibody Type | Monoclonal |
| Clone | D-5 |
| Source | Mouse |
| Tissue Type/Cancer Type | Breast carcinoma |
| Pack | 6 mL (RTU), 100 Tests – Automation – i6000, 1 mL(Conc.), 0.5 mL (Conc.), 160 tests – Xmatrx Elite, 50 tests – NanoVIP, 50 tests – Xmatrx Elite, 5 slides – Xmatrx, 5 slides – Manual |